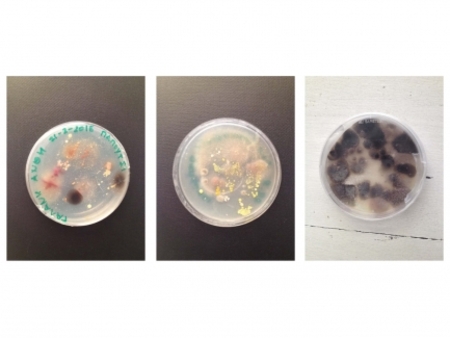
all the landscapes you are

-
info
Becoming a Sentinel Species is a fictional story imagining a future in which humans explore and reflect on the role of the sentinel as an eye witness to environmental pollution. The film follows two researchers who experimentally introduce microplastics collected from the sea into their own bodies. In order to "become sentinels" they isolate macrophages from blood and contaminate them with microplastics in a laboratory setting. The film weaves in documentary footage of the making of an actual human biomarker to microplastics, using macrophages (the immune system's "first responders") grown from the artist's blood. Project by Sissel Marie Tonn in collaboration with Heather A. Leslie & Juan J. Garcia Vallejo. Producer: Victoria Douka-Doukopoulou. Cinematography: Casper Brink. Performers: Kenzo Kusuda & Goda Žukauskaitė. Sound, Electronic Music Score & Foley: An3_at & Yun Lee. Sound Mixing and Mastering: An3_at. Electro-acoustic score: Vincenzo Castellana. Laboratory technician: Marlous van den Braber. Microscopy: Marko Popovic. Glass blown objects: Geir Nustad
-
info
Becoming a Sentinel Species is a fictional story imagining a future in which humans explore and reflect on the role of the sentinel as an eye witness to environmental pollution. The film follows two researchers who experimentally introduce microplastics collected from the sea into their own bodies. In order to "become sentinels" they isolate macrophages from blood and contaminate them with microplastics in a laboratory setting. The film weaves in documentary footage of the making of an actual human biomarker to microplastics, using macrophages (the immune system's "first responders") grown from the artist's blood. Project by Sissel Marie Tonn in collaboration with Heather A. Leslie & Juan J. Garcia Vallejo. Producer: Victoria Douka-Doukopoulou. Cinematography: Casper Brink. Performers: Kenzo Kusuda & Goda Žukauskaitė. Sound, Electronic Music Score & Foley: An3_at & Yun Lee. Sound Mixing and Mastering: An3_at. Electro-acoustic score: Vincenzo Castellana. Laboratory technician: Marlous van den Braber. Microscopy: Marko Popovic. Glass blown objects: Geir Nustad
-
info
On Thursday 5 July 2018 between 23:00 and 00:00 CEST we set off to transverse the atmospheric levels for the radio prologue of Eline Benjaminsen & Sophie Dyer — RADIO, TECHNO, FOSSIL at Het Schimmengebied hosted by Duistere Bardo on Radio Tonka 92.0 Den Haag FM. Amongst other, the hour-long radio program featured pieces by Dr. Matt Rogalsky & Dr. Laura Cameron, Emptyset and Daniele Guerrini & Matthias Girardi and welcomed lecturer in GeoHumanities at Royal Holloway, University, Sasha Engelmann as a program contributor.
-
info
Meaning Seeking Animals explores the possibility of a publication as a world, it is a personal collection of digested knowledge that keeps on growing as Lisa van Casand proceeds to make new work. The publication could be thought along the more traditional or fa- miliar notions of a notebook, diary or log — but as a collection of knowl- edge it is much closer to how Walter Benjamin envisioned the dream world “an autonomous world of dreams circling the earth at night”. Audience members during the silent-disco lecture installation of the publication.
-
info
Radio, Techno, Fossil tells the story of a radio-image as it traverses the bounds of the Earth’s surfaces, atmospheres and techno-geographies. The publication tunes into our highly textured and complex radio environment by subjecting itself to the unpredictability, seasonality, solar circles of the ionosphere and the current location of the reader. The publication embeds itself by using real time ionospheric measurements to determine how much publication and how much environment arrives.
-
info
acatalog.allthingsinvisible.online complies stories of the invisible, the unthinkable and the inappreciable.
-
info
acatalog.allthingsinvisible.online complies stories of the invisible, the unthinkable and the inappreciable.
-
info
‘So let’s say, you walk down a path and you run into a snag, a dead tree, an unexpected drawback — a soarvi’ begins with us already in conversation, yet it doesn’t matter what we were discussing before diving in. Before running into the soarvi, the big or peculiar dead tree that will remain a point of references in our walk. It is a non-linear exploration of ways to express thoughts like walks, ways to tell a story about time that involve getting to know all the participants — human and non human. A triple story; that of the landscape, Sámi and Western Science. In the slow pace of walking it works through time scales, from the pattern of forest developments to SI seconds, offering a peek into otherness.
-
info
Poetics and Politics of Erasure is a multidisciplinary essay by Yun Lee on the aesthetics and politics of erasure. The framework for erasure is drawn from a critique of accelerationism, the video game Katamari Damacy, and internet aesthetics. It begins by investigating power relations in dominant archival practices, before tracing how memory storage technology (from the written word to the internet) reinforces hierarchical models of knowledge, and finally posing the generative potential of erasure in alternative models of knowing, doing, and being. It does so by locating strategies of erasure in audio, visual, and digital cultures in the forms of: erasure/ forgetting, translation/mutation, and recontextualizing/remythologizing. In an online terrain that seems to permanently exist in the paradigm between the lack of long-term preservation and the increasing realisation that ‘the internet never forgets’. Poetics and Politics of Erasure situates itself in erasure as practice — slowly and collectively — upon each visit, each read and each refresh the work deletes itself. And as bits of the essay are changed or lost, new meaning is created. Continuing with this collective erasure until the page is blank.
-
info
“New media—we are told—exist at the bleeding edge of obsolescence. We thus forever try to catch up, updating to remain the same”, wrote Wendy Chung in Updating to Remain the Same: Habitual New Media in 2016. Karina Zavidova wrote Artificial Intelligence Never Has A Headache as her bachelor thesis in 2016, and saw that bleeding age up close. Now in 2018 she is revisiting the original text, so many things have been updated, so many things have remained the same, yet her mode of existence has not. The publication imagines a possible future format for tech related theory which — with the constant updates of technology— tend to see the edge of obsolescence straight out of the publisher’s door. Borrowing from version technologies and software lingo, the publication explores what an edition would mean or look like when it occurs as often as update rollups. Over the next couple months, the author will keep a leisurely eye on the publication making sure it remains updated and “running”, as one would do upkeeping a plug in.
-
info
research project exploring unseen organic landscapes.
-
info
Nitrate film base dominated the motion picture industry until the late 1950s. Nitrate was highly flammable and could ignite spontaneously even at low temperatures, so it was also a good replacement for gunpowder as an explosiveused in mining. Because of its combustibility, projection rooms needed to be fireproof with wall coverings made ofasbestos. The mysterious 120 frames of a decomposing nitrate film about the first Dutch apostle mission to California – discovered in the EYE Film Institute in Amsterdam – serve as a starting point for the material study of the nitrate film base. A single wave crashing into the shore, hand-scanned from the red negative, acts as a hypnotic sample of once luscious cinematic nitrate landscapes. The endless loop in which the wave is trapped reminds us of the stories lost in the nitrate fires and the acid decomposition of the material.
-
info
Nitrate film base dominated the motion picture industry until the late 1950s. Nitrate was highly flammable and could ignite spontaneously even at low temperatures, so it was also a good replacement for gunpowder as an explosiveused in mining. Because of its combustibility, projection rooms needed to be fireproof with wall coverings made ofasbestos. The mysterious 120 frames of a decomposing nitrate film about the first Dutch apostle mission to California – discovered in the EYE Film Institute in Amsterdam – serve as a starting point for the material study of the nitrate film base. A single wave crashing into the shore, hand-scanned from the red negative, acts as a hypnotic sample of once luscious cinematic nitrate landscapes. The endless loop in which the wave is trapped reminds us of the stories lost in the nitrate fires and the acid decomposition of the material.
Her artistic practice has been following the methodologies and traditions of expanded cinema, looking closely into networks and systems to locate entry points, to “expand the system” and allow possibilities for discovery of alternative instances and experiences. But rather than staying solemnly with video or film, attempting to apply this “expansive” methodology to other media like publications or digital objects, using those instances to create moments for media to entangle with other media presentations and spectatorships. Making films that require from the viewer the engagement of a book, books that allow the reader the participatory navigation of a website, and websites that demand the spectatorship of a traditional cinematic experience.
Thematically much of her work make uses of this “expansive” intermedia practices to assemble and communicate, a sensitivity towards noticing, an understanding, an education in attention. The works could be thought as gestures or nudges towards caring deeply and engaging mindfully as the world is full of potential knowledge sites. Possibly found in unconventional places like the side of the road, blending into the surrounding grey, tentatively "discovered" on page 44 of Volume 33 of Project and Site Description HKN; Appendix C, Boundaries and Coordinates - version August 15, 2019 (Word file). Of Human or more-than-human authorship, like the “HARMFUL/ TOXIC TO BE CAREFULLY DISPOSED” bin of the Eye Filmmusuem Archive or the 11 000 old hill that has always been island.
Websites
Maakt deel uit van Kunstenaarsinitiatief / Collectief / Broedplaats
oneacre.online
Curriculum vitae
Opleidingen
-
2013 - 2017Artscience Den Haag, Koninklijke Academie van Beeldende Kunsten Diploma behaald
-
2010 - 2012Environmental Design/ Graphic Design Maryland Institute College of Art, USA
-
2015Artic Studies/ Fine Art University of Lapland,Finland
tentoonstellingen
-
2020The Reading Room #34: The Art of Noticing See Lab Den Haag, Nederland reading + film screening
-
2020Worlds of Ursula K. Le Guin FIBER FESTIVAL x LAB111 Amsterdam, Nederland introduction lecture www.lab111.nl/fiber/
-
2020Evolutionaries : Bio Art & Design Award MU Eindhoven Eindhoven, Nederland Becoming a Sentinel Species [Film], Dir. Sissel Marie Tonn Producer. Victoria Douka-Doukopoulou mu.nl/en/exhibitions/evolutionaries Groep
-
2019Multispecies Storytelling in Intermedial Practices Linnæus University Vaxjo, Zweden conference contribution + film screening Groep
-
2019
-
2019Mark as Unread: Online Publishing as Artistic Practice Page Not Found Den Haag, Nederland artist's lecture Duo
-
2018OpZicht: Victoria Douka-Doukopoulou Stroom Den Haag The Hague, Nederland exhibition www.stroom.nl/activiteiten/kleine_presentatie.php?kt_id=3135954 Solo
-
2018Ephémère Studio LOOS The Hague, Nederland film screening www.studioloos.com/mc-events/2030-concert-series-ephemere-guest-curator-marit-mihklepp-with-ingrid-eel-flora-reznik-and-victoria-douka-doukopoulou Groep
-
2018ᴏɴᴇᴀᴄʀᴇ.ᴏɴʟɪɴᴇ Artificial Intelligence Never has a Headache : Grey Space in The Middle Den Haag, Nederland publication launch + reading Solo
-
2018Stedelijk Book Club: Press! Print! Publish! Stedelijk Museum Amsterdam publication launch + lecture Groep
-
2017ᴏɴᴇᴀᴄʀᴇ.ᴏɴʟɪɴᴇ RADIO, TECHNO, FOSSIL : Eline Benjaminssen & Sophie Dye Witte de With, Center for Contemporary Art Rotterdam , Nederland publication launch + reading www.fkawdw.nl/en/our_program/events/talk_radio_techno_fossil Solo
-
2017ᴏɴᴇᴀᴄʀᴇ.ᴏɴʟɪɴᴇ Poetics and Politics of Erasure : Yun Lee LhGWR Den Haag, Nederland publication launch + performance Solo
-
2016TENTION MACHINES Zaal 3 Den Haag, Nederland performance Groep
-
2015KABK: RESEARCH LAB ON EYE Eye Film Museum Amsterdam, Nederland film screening Groep
-
2015Welcome to Ecumenopolis TAF Foundation Athens, Griekenland workshop Groep
-
2015BARTALK Den Haag, Nederland performance lecture Groep
-
2014THE THEATRE MACHINE Zaal 3 Den Haag, Nederland performance Groep
-
2014SONIC AIR SPACES TU/e Eindhoven Eindhoven, Nederland performance installation Groep
-
2014ALGAE WORKSHOP Waag Society Amsterdam, Nederland workshop Groep
-
2014MADCOW De Compagnie (CHV- terrein) Veghel, Nederland performance Groep
projecten
-
2020
Becoming A Sentinel Species BAD Award Nederland sisselmarietonn.com/project/becoming-a-sentinel-species
Plastic pollution in the Earth’s oceans has become a part of marine species’ daily experience. These species act as sentinels, informing scientists who seek to understand the impacts of plastic in the field. Plastic pollution crisscrosses marine and terrestrial realms, and is likewise a part of the human experience. Nascent research indicates that tiny microplastic particles may also be entering the human “inner ocean” - the bloodstream.
Becoming a Sentinel Species suggests an expanded awareness of our world and all its intertwined sentinels may lead to a reconnection with our shared deep past, enabling an exuberant multi-species coexistence on Earth. The human health impacts of microplastics are yet to be elucidated, but their presence in our bodies and surroundings is a potent reminder that we are not impenetrable entities, but rather fluid organisms - no more pure than the environments we co-create. We have, in a sense, always been sentinels.
Project by Sissel Marie Tonn in collaboration with Heather A. Leslie & Juan J. Garcia Vallejo.
Producer: Victoria Douka-Doukopoulou.
Cinematography: Casper Brink.
Performers: Kenzo Kusuda & Goda Žukauskaitė.
Sound, Electronic Music Score & Foley: An3_at & Yun Lee.
Sound Mixing and Mastering: An3_at.
Electro-acoustic score: Vincenzo Castellana.
Laboratory technician: Marlous van den Braber.
Microscopy: Marko Popovic.
Glass blown objects: Geir Nustad
-
2016
oneacre.online oneacre.online Nederland catalogue.oneacre.online
oneacre.online is an experimental publishing & distribution project that utilises an online platform to seed unprintable text-based works by emerging artists.
Thematically oneacre.online first four commissioned publications place themselves in the online world of constant updates and refresh buttons that, as theorist Wendy Chun observes, “exist at the bleeding edge of obsolescence. We thus forever try to catch up, updating to remain the same”. The publications use the omnidirectional online terrain and actions that are native to it — such as refreshing, instantly available to edit, easily erasable, highlighting, copy-pasting and non linear navigation — to explore and critically evaluate visions and versions of power systems by tracing the politics of technological infrastructures.
The series showcased in December 2017 ᴛʜᴇ ᴘᴏᴇᴛɪᴄs ᴀɴᴅ ᴘᴏʟɪᴛɪᴄs ᴏғ ᴇʀᴀsᴜʀᴇ by Yun Lee, a multidisciplinary research paper on the aesthetics and politics of erasure. In March 2018, ᴀʀᴛɪғɪᴄɪᴀʟ ɪɴᴛᴇʟʟɪɢᴇɴᴄᴇ ɴᴇᴠᴇʀ ʜᴀs ᴀ ʜᴇᴀᴅᴀᴄʜᴇ by Karina Zavidova, a long-form about the fear of AI spread by the media, and the market of productivity- enhancing tools it has fuelled. In June 2018 ʀᴀᴅɪᴏ, ᴛᴇᴄʜɴᴏ, ғᴏssɪʟ by Eline Benjaminsen & Sophie Dyer, the story of a radio-image as it traverses the bounds of the Earth’s surfaces, atmospheres and techno-geographies. And finally in September 2018, ᴍᴇᴀɴɪɴɢ-sᴇᴇᴋɪɴɢ ᴀɴɪᴍᴀʟs by Lisa van Casand, a subjective collection of a wide range of perspectives on the transfer of information.
Internationale uitwisselingen / Artist-in-residencies
-
2015Nadine, Belgium Brussels, België Default is a series of journeys following a straight line: a fold in a map of Europe. This journey follows a straight line throught Ireland. From the North to the South coast.
Aankopen/werken in collecties
-
2015nitrocellulose Eye Film Museum Amsterdam, Nederland film
publicaties
-
2021Acousmonium kulturpunkt.hr Victoria Douka-Doukopoulou Zagreb, Kroatië www.kulturpunkt.hr/content/acousmonium Translation: Miona Muštra
-
2021Devin Hentz: Situating Fashion Boek Sonic Acts Press Victoria Douka-Doukopoulou & Pim Set Benjamin Amsterdam, Nederland sonicacts.com/sashop/product/ecoes/ in Ecoes # 1 Ed. Mirna Belina, Introduction Text
-
2021Angela Chan: Communal Climate Knowledges Boek Sonic Acts Press Victoria Douka-Doukopoulou & Angela Chan Amsterdam, Nederland sonicacts.com/sashop/product/ecoes/ in Ecoes # 1 Ed. Mirna Belina, Introduction Text
-
2019The Acousmonium: Another Utopia, Devoted to Pure Listening Boek Sonic Acts Press Victoria Douka-Doukopoulou Den Haag, Nederland sonicacts.com/sashop/product/book-hereafter-sonic-acts-2019/ in HEREAFTER: Sonic Acts Reader, Ed.Mirna Belina. Essay
-
2019Sonic Acts 1994–2019: Participating artists and authors Boek Sonic Acts Press Arie Altena & Lucas van der Velden Amsterdam, Nederland sonicacts.com/sashop/product/book-hereafter-sonic-acts-2019/ in HEREAFTER: Sonic Acts Reader, Ed.Mirna Belina. Archival Research
-
2019Sonic Acts and the Changing Role of Festivals Boek jap sam books Arie Altena & Lucas van der Velden Amsterdam, Nederland www.japsambooks.nl/products/a-critical-history-of-media-art-in-the-netherlands-platforms-policies-technologies in A Critical History of Media Art in the Netherlands Eds.Sanneke Huisman, Marga van Mechelen. Archival Research
-
2018Meaning Seeking Animals oneacre.online Lisa van Casand Den Haag, Nederland www.oneacre.online/catalog/meaning-seeking-animals Ed. Victoria Douka-Doukopoulou
-
2017RADIO, TECHNO, FOSSIL oneacre.online Eline Benjaminsen & Sophie Dyer Den Haag, Nederland www.oneacre.online/catalog/radio-techno-fossil Ed. Victoria Douka-Doukopoulou
-
2017Artificial Intelligence Never Has A Headache oneacre.online Karina Zavidova, Den Haag, Nederland www.oneacre.online/catalog/artificial-intelligence-never-has-a-headache Ed. Victoria Douka-Doukopoulou
-
2017Poetics and Politics of Erasure oneacre.online Yun Lee Den Haag, Nederland www.oneacre.online/catalog/poetics-and-politics-of-erasure Ed. Victoria Douka-Doukopoulou
-
2017so let's say, you walk down a path and you run into a snag, a dead tree, a unexpected drawback — a soarvi Boek self-published Victoria Douka-Doukopoulou Den Haag, Nederland
-
2016part preface /part acknowledgements oneacre.online Victoria Douka-Doukopoulou Den Haag, Nederland www.oneacre.online/announcement Essay
-
20141st WABook Catalogus Nadine Brussels, België index.nadine.be/1st-wabook/ Ed. Pacôme Béru, Loes Jacobs
-
2013TKTNK one: Intersection Columbia + Barnard College Underground journal Boek Columbia + Barnard College, USA Victoria Douka-Doukopoulou New York, Verenigde Staten Review
Recensies
-
2018Böcker lika konstfulla som sitt innehåll Krant Kristoffer Leandoer Malmo, Zweden www.svd.se/bocker-lika-konstfulla-som-sitt-innehall
-
2018DEAR READER Radio Ja Ja Ja Nee Nee Nee Amsterdam, Nederland www.jajajaneeneenee.com/jn/shows/stedelijk-book-club-18/
-
2017Examenexpositie Den Haag: de tennisbaan is gek geworden Blog/Vlog Dirk Limburg Nederland www.nrc.nl/nieuws/2017/07/02/531853-a1565277
Prijzen en stipendia
-
2018Stroom Den Haag SPOT STROOM, Den Haag Den Haag, Nederland
-
2018Stroom Den Haag Stroom PRO Kunstprogramma Grant Den Haag, Nederland
-
2017Digital Culture Grant Stimulering Fonds Den Haag, Nederland
-
2017Stroom Den Haag Stroom Encouragement Award Den Haag, Nederland
-
2011Maryland Institute College of Art Returning Student Scholarship
-
2011Maryland Institute College of Art MICA Grant Baltimore, Verenigde Staten
-
2010Maryland Institute College of Art Presidential Scholar Baltimore, Verenigde Staten
-
2010Maryland Institute College of Art International CV Starr Scholar Baltimore, Verenigde Staten
artistieke nevenactiviteiten
-
2019 - --Stichting BARTALK — board member Loopt nog
-
2018 - --Sonic Acts Festival — archive, research and curatorial team Loopt nog
-
2016 - 2017Witte de With Class of '17 —peer-led education initiative— programmer
-
2016 - --oneacre.online — co founder & editor Loopt nog
-
2014 - 2015CASS — concert series —programmer